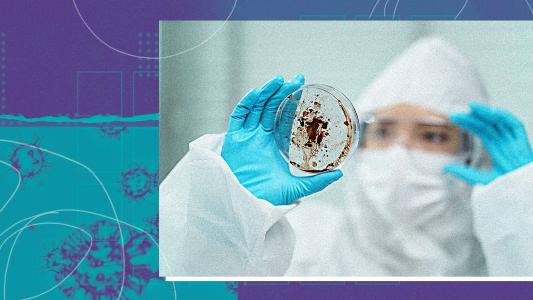

Coronavirus
Will the coronavirus end in the summer?
Will the coronavirus end in the summer as a result of warmer temperatures? The public is hopeful, but here’s what the experts say.
A proposal to infect volunteers, the race to a vaccine, and more COVID-19 updates
In our weekly news roundup, we take you inside the fight against COVID-19 to explore the solutions on the frontlines of an unprecedented global response.
Where can you get tested for the coronavirus?
Everything you need to know to get tested for the coronavirus, including COVID-19 testing requirements and resources to help you find testing sites.
Why the MLB antibody study matters
10,000 MLB employees, from players to concession stand attendees, are volunteering to help scientists study how COVID-19 has spread throughout the country.
Every significant breakthrough that’s stemmed from the pandemic
A timeline of coronavirus solutions from the people on the frontlines of the fight against COVID-19.
Oxford coronavirus vaccine could be ready by September
Millions of doses of an Oxford coronavirus vaccine now in the human trial stage could be ready by September, according to researchers.
Twin study suggests genes factor into COVID-19 symptoms
Genetic factors may explain about 50% of the differences in people’s COVID-19 symptoms, according to a study of more than 2,600 twins in the U.K.
An “old school” COVID-19 vaccine appears to work in monkeys
An in-development COVID-19 vaccine has protected animals from catching the novel coronavirus for the first time, according to the team behind it.
Tons of groups are improvising coronavirus PPE. But who will test it?
A newly formed group is gathering designs for coronavirus PPE and coordinating with testers to make sure the makeshift supplies are safe for use.
DNA might be able to explain varying coronavirus symptoms
Scientists are looking for genetic factors that could explain varying coronavirus symptoms amongst seemingly similar COVID-19 patients.